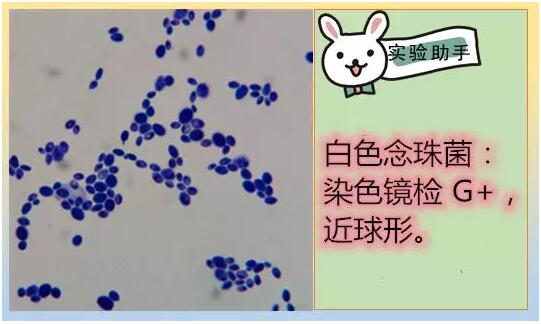

海博微信公众号
海博微信公众号
 海博天猫旗舰店
海博天猫旗舰店


 海博微信公众号
海博微信公众号
 海博天猫旗舰店
海博天猫旗舰店




微生物菌体形态观察是微生物学基本操作。菌体形态的检查过程一般经过涂片、染色和显微镜检。总体而言,微生物染色方法一般分为单染色法和复染色法两种。前者用一种染料使微生物染色,但不能鉴别微生物,如乳酸酚棉兰染色液,用于真菌的染色。复染色法是用两种或以上染料,能协助鉴别微生物。常用法有革兰氏染色法,还有鉴别细胞各部分结构如芽孢、鞭毛、荚膜等特殊染色法。
微生物染色方法各式各样,本文着重介绍
1) 革兰氏染色法
2) 乳酸酚棉蓝染色法
3) 芽孢染色法
4) 鞭毛染色法
5) 荚膜染色法。
一、革兰氏染色法

1 操作步骤
革兰氏染色法,是指细菌学中广泛使用的一种重要的鉴别染色法。不仅能观察到细菌的形态而且还可将所有细菌区分为两大类:染色反应呈蓝紫色的称为革兰氏阳性细菌,用G+表示,染色反应呈红色(复染颜色)的称为革兰氏阴性细菌,用G-表示。细菌对于革兰氏染色的不同反应,是由于它们细胞壁的成分和结构不同而造成的。革兰氏阳性细菌的细胞壁主要是由肤聚糖形成的网状结构组成的,在染色过程中,当用乙醇处理时,由于脱水而引起网状结构中的孔径变小,通透性降低,使结晶紫一碘复合物被保留在细胞内而不易脱色,因此,呈现蓝紫色;革兰氏阴性细菌的细胞壁中肤聚糖含量低,而脂类物质含量高,当用乙醇处理时,脂类物质溶解,细胞壁的通透性增加,使结晶紫一碘复合物易被乙醇抽出而脱色,然后又被染上了复染液(番红)的颜色,因此呈现红色。
一般挑选16-24h内的新鲜培养物进行。镜检应采用油镜进行,放大倍数为1000倍。
涂片:将培养的不同菌分别作涂片(注意涂片切不可过于浓厚),干燥、固定。固定时通过火焰1-2 次即可,不可过热,以载玻片不烫手为宜。
初染:加结晶紫液盖满标本处,染一分钟后水洗,并将玻片上积水轻轻甩净。
媒染:加碘液盖满标本处,1分钟后水洗,甩净玻片上积水。
脱色:加95%酒精盖满标本,轻轻摇动玻片,约20秒钟后水洗、甩干。
复染:加稀释石炭酸复红液或沙黄溶液1-2滴盖满标本,染30秒钟后水洗,待标本自干或用吸水纸印干。
观察:镜检干燥后置油镜观察,革兰氏阴性菌呈红色,革兰氏阳性菌呈紫色。以分散开的细菌的革兰氏染色反应为准,过于密集的细菌,常常呈假阳性。
细菌有三种基本形态,即球形、杆形和螺旋形,分别称为球菌、杆菌和螺形菌。具体如图1所示:

图1. 细菌菌体特征
1.微球菌 2.葡萄球菌 3.双球菌 4.链球菌 5.四联球菌 6.八叠球菌 7.杆菌 8.球菌 9.链杆菌 10.梭状杆菌
11.棒状杆菌 12.芽孢杆菌 13.破伤风棱菌 14.弧菌 15.螺菌 16.荚膜 17.菌鞭毛
二、乳酸酚棉蓝染色法

1 操作步骤
染色:于洁净载玻片上,滴1-2滴乳酸酚棉蓝染色液,用解剖针从霉菌菌落的边缘外取少量带有 孢子的菌丝置于染色液中,再细心地将菌丝挑散开,然后小心地盖上盖玻片,注意不要产生气泡。置显微镜下先用低倍镜观察,必要时再换高倍镜。
观察:染好后的标本片用显微镜观察结果,酵母菌细胞、菌丝体和产孢结构等皆可被染成亮蓝色;背景为暗淡的蓝色。

图2. 乳酸酚棉蓝染色实物图

图3 曲霉菌体形态图
1.分生孢子 2.次生小梗 3.初生小梗 4.顶囊 5.分生孢子梗 6.足细胞
三、芽孢染色法

1 操作步骤
一般革兰氏染色只能把芽孢周围的细胞质染色,不能直接把芽孢染上,故芽孢会透亮,能够观察到芽孢。若不清晰可进一步采用芽孢染色法。
染色:用接种环取菌样涂布于玻片上,待自然干燥。而后通过火焰加热将菌固定于玻片上。将涂片放入平皿内,片上放两层滤纸,滴加足量的5.0%孔雀绿水溶液。将平皿盖好,54℃-56℃水浴加热30min。取出,去滤纸,用纯化水冲洗残留孔雀绿溶液。加0.5% 沙黄水溶液,染1min。水洗,待干后油镜观察。
观察:染好后的标本片用显微镜观察结果,芽孢呈绿色,菌体呈红色。

图4.芽孢染色实物图
许多细菌(如芽孢杆菌等)发育到某一阶段,在细胞内形成一个圆形或椭圆形,抗逆性强的休眠体构造,称为芽孢。芽孢着生的位置、形状、大小因菌种不同而异。一般分为中央芽孢、末端芽孢、偏端芽孢、游离芽孢等。

图5 细菌芽孢的各种类型
四、荚膜染色法

荚膜(capsule)是某些细菌表面的特殊结构,是位于细胞壁表面的一层松散的粘液物质,荚膜的成分因不同菌种而异,主要是由葡萄糖与葡萄糖醛酸组成的聚合物。
涂片:按常规法涂片,可多挑些菌体与水充分混合,并将粘稠菌液尽量涂开,涂布面积不宜过大。
干燥:在空气中自然干燥。
染色:用溶液A染5-7分钟。
脱色:用溶液B洗去结晶紫,脱色要适度(冲洗2遍)。用吸水纸吸干,并立即加1-2滴香柏油于涂片处,以防止CuSO4结晶的形成。镜检。
观察:背景蓝紫色,菌体紫色,荚膜无色或浅紫色。

图6 荚膜细菌结构图
五、鞭毛染色法

长在某些细菌菌体上细长而弯曲的具有运动功能的蛋白质附属丝状物,称为鞭毛。许多细菌都是运动的,通常使用鞭毛移向营养物质。鞭毛很薄,不易染色和观察。
涂片:取幼龄细菌培养物制成涂片。
干燥:火焰干燥及固定。
染色:鞭毛染色液2-3滴,在室温中染色2-3分钟。
脱色:水洗,干燥后镜检(油镜)。
观察:菌体和鞭毛呈紫色。

图5 蜡样芽孢杆菌鞭毛染色图

图6 细菌鞭毛着生方式

上一篇:史上最全实验室安全说明书!



